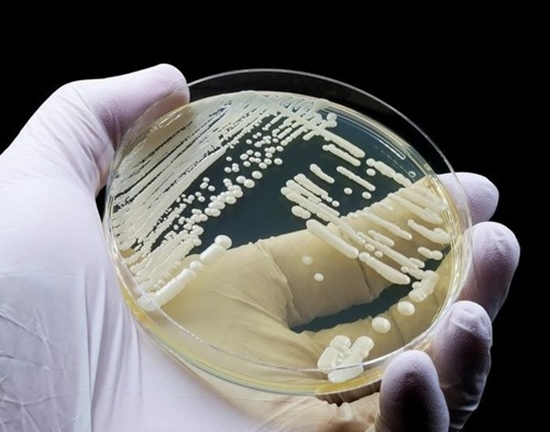

جداسازی و شناسایی گونه کاندیدا اوریس از نمونه های بالینی با استفاده از روش های وابسته به کشت ده درصد نمکدار CHROMagar Candida Plus , Sabouraud Dextrose Broth و تایید با روش های مولکولی تعداد بیماران بستری در بیمارستان های تهران در سال 1402-1403
مرکز هدف اول: م ت. مقاومت میکروبی و مدیریت مصرف آنتی بیوتیک ها
خلاصه ضرورت اجرای طرح:
بروز عفونتهای قارچی مهاجم به دلیل بالا رفتن بیماران مبتلا به عفونتهای قارچی در مراکز درمانی در حال افزایش است. فانگمی بعنوان شایع ترین عفونت قارچی مهاجم اغلب ناشی از گونه های کاندیدا میباشد. C. auris در سطح جهانی به عنوان یک پاتوژن قارچی مرتبط با مراقبتهای بهداشتی مقاوم در برابر چند دارو در کشورهای زیادی با clade های متفاوت ظاهر شده است بررسی های نشان می دهد (clade) کلاد پنج این گونه در ایران شیوع بیشتری داشته است گزارشهای اخیر چالشهای مداوم ناشی از شناسای ناصحیخ ارگانیسم میزان بالای مقاومت دارویی ضد قارچی و مرگ و میر قابل توجه بیماران را برجسته می کند. تمایل به انتقال در داخل و بین مراکز مراقبت بهداشتی که احتمالاً توسط عوامل بیماری زای ایجاد میشود که کلونیزاسیون و تداوم محیطی را تسهیل می کنند، در میان گونه های کاندیدا منحصر به فرد است. متاسفانه به دلیل نرخ بالای شکست درمانهای ضد قارچی علیه گونه های C. auris، شناسایی سریع و دقیق بیماران کلونیزه شده با C. auris برای غلبه بر چالش جلوگیری از انتقال بسیار مهم است تنها با روشهای اختصاصی و استاندارد PCR اختصاصی میتوان با موفقیت برای تشخیص سریع و دقیق C. auris به طور مستقیم در نمونه های بیمار استفاده کرد و سویه C. auris را می توان از گونه های نزدیک متمایز کند ظرفیت تشخیصی آزمایشگاهی میکروبیولوژیک فراتر از روشهای مبتنی بر کشت و تهیه گسترش است و شامل PCR اختصاصی و توالی یابی میشود تشخیص آزمایشگاهی معمولاً با میکروسکوپ و کشت انجام می شود. با این حال محیط کشتهای شناسایی کننده مورد استفاده به اندازه کافی اختصاصی نیستند تا به طور قابل اعتماد عوامل ایجاد کننده را متمایز کنند به ویژه برای پاتوژنهای نادر مانند C. auris میزان دقیق وقوع عفونتهای C. auris ، عمدتاً به دلیل نقص در ابزارهای تشخیص و شناسایی که به طور معمول استفاده میشود هنوز مشخص نمی باشد. هدف از مطالعه حاضر شناسایی و جداسازی گونه C. auris از نمونه های بالینی مستقیم بیماران مشکوک به عفونت مخمری C. auris توسط راه اندازی محیط کشت اختصاصی انتخابی (سلکتیو) جهت رشد این گونه در آزمایشگاه بصورت روتین و تایید توسط روشهای مولکولی و PCR اختصاصی است.
خلاصه روش اجرا:
نوع مطالعه: مقطعی
سال: بهمن ماه ۱۴۰۲ الی ۱۴۰۳
مکان: بخش قارچ شناسی دانشکده بهداشت
جمعیت مورد مطالعه: بیماران مشکوک به عفونت کاندیدیازیز بستری شده در بیمارستانهای منتخب دانشگاه علوم پزشکی تهران
۱- جمع آوری نمونه های بالینی از جمله محتویات گوش بیماران مشکوک به عفونتهای قارچی گوش و انتقال آنها با حفظ زنجیره سرد در کمتر از ۲ ساعت به آزمایشگاه قارچ شناسی
2- کشت نمونه ها بر روی محیطهای سابورو دکستروز آگار (SDA) و سابورو دکستروز مایع ۱۰% نمکدار ((SDDB
3- بررسی محیط های کشت از جهت رشد کردن کلنی مخمری گونه کاندیدا اوریس
4- کشت نمونه های مثبت رشد کرده از محیط سابورو دکستروز مایع ۱۰ نمکدار (SDDB) بر روی محیط کروموژنیک کروم آگار کاندیدا پلاس
5- تایید هویت کلونیهای رشد کرده بروی محیطهای مذکور بواسطه PCR اختصاصی گونه کاندیدا اوریس
مجری طرح: دکتر صادق خداویسی
اولویت: مطالعات مقاومت های داوریی میکروارگانیسم های بیماریزا
نوع طرح: بنیادی کاربردی



ارسال نظر